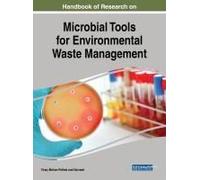
Handbook Of Research On Microbial Tools For Environmental Waste Management

![Handbook on Waste Management (Elgar Original Reference) - [Livre en VO] Thomas Kinnaman, Kenji Takeuchi, K Takeuchi (Auteur)](https://cdn.prix.net/offer/fr/handbook-on-waste-management-elgar-original-reference-livre-en-vo-thomas-kinnaman-kenji-takeuchi-k-t-200t180c87d1fe6141eb9d12e080498a9f21c5960d93bff.jpg)









🤖 Demande à ChatGPT
waste: a handbook - Comparez les prix parmi 35 offres disponibles chez nos partenaires et achetez moins cher.
Quel est le meilleur prix pour waste: a handbook ?
Parmi toutes nos offres du 2026-01-14, le prix très intéressant de 10,54 € vient de Amazon.fr. Les périodes de Soldes ou le Black Friday offrent généralement de meilleurs prix.
Vous pourrez commander waste: a handbook au meilleur prix chez Amazon.fr et bien d'autres.
Nous, chez prix.net, avons sélectionné pour vous parmi nos 4, les magasins les plus appropriés pour vos achats! Regardez les offres de Rakuten.com FR, Amazon.fr et amazon-marketplace.fr pour commander waste: a handbook. Ceci n'est qu'une petite partie de tous les partenaires référencés sur ce comparateur de prix. Choississez vos marchand préféré parmi tous les filtres.
Liste des marchands proposant la recherche waste: a handbook:
- Rakuten.com FR
- Amazon.fr
- amazon-marketplace.fr
- Fnac.com (Marketplace)
waste: a handbook Amazon.fr
waste: a handbook est disponible sur Amazon.fr. Seul les marchands remplissant des garanties de livraison, de protection de paiement et de bons retours d'utilisateurs sont proposés sur prix.net
waste: a handbook est en vente en ligne et est proposé par plusieurs marques sur internet.
Aucune marque n'est renseigné pour la recherche de ce produit ou de ce mot-clé. Vous recherchez une marque bien précise ? Utilisez à nouveau la zone de recherche pour obtenir d'autres résultats.
Il n'y a pas de recherche similaire à cet requête. Choississez un autre produit le moteur de recherche de produit de prix.net si vous êtes intéressé par un produit ressemblant ou s'y raprochant.
Aucun renseignement concernant une couleur est indiqué ou renseigné par le marchand en ligne pour cette requête.
Comparer les prix avant tous achats en ligne
Un comparateur de prix, comme prix.net, vous propose de comparer et de trouver le meilleur prix sur le net. Prenez le réflexe de comparer les prix avant de passer commande. Vous aurez alors accès à toutes les offres proposées par nos marchands partenaires. Ainsi vous pourrez faire de bonnes affaires en direct. Sous chaque frais, vous aurez des informations utiles pour vos achats en lignes, comme par exemple les modes de règlement de vos achats et les délais et conditions de livraison. Comparez, cliquez et finalisez vos achats chez le E-commerçant.
Comment fonctionne notre comparateur de prix ?
Trouver les meilleurs prix sur le net peut être parfois long et pénible. Un comparateur de prix comme prix.net, vous permettra de faire de grands économies. Vous gagnerez également un temps précieux. Quoi de mieux ? Nous analysons plusieurs de dizaines de fois par jour des centaines de milliers de prix de produits et d’offres sur le net parmi nos partenaires. Recherchez un produit et nous vous indiquerons le prix le plus actuel parmi des centaines de marchands du web.